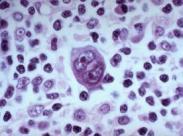
小兒非霍奇金淋巴瘤

非霍奇金淋巴瘤(non-Hodgkinslymphoma,NHL)又稱惡性淋巴瘤,起源于增殖分化過程中的淋巴細(xì)胞,它的擴散方式與相應(yīng)的正常淋巴細(xì)胞移行方式相似。
- 外文名:
- 就診科室:腫瘤科
- 傳染性:無
- 多發(fā)群體:
- 常見病因:
- 常見癥狀:消瘦、淋巴結(jié)腫大、肢體疼痛、出血傾向、肝脾腫大、面部水腫上肢水腫
- 人氣指數(shù): 人
- 更新日期:2023.12.07 11:43
- 疾病介紹
疾病標(biāo)簽:
-
小兒非霍奇金淋巴瘤,小兒非霍奇金淋巴瘤癥狀
相關(guān)疾病
-
肛管癌
628健康網(wǎng)為您分享有關(guān)肛管癌的癥狀,肛管癌的治療方法,肛管癌的預(yù)防知識,肛管癌的癥狀圖片,肛管癌吃什么藥,肛管癌怎么治...
-
汗腺癌
628健康網(wǎng)為您分享有關(guān)汗腺癌的癥狀,汗腺癌的治療方法,汗腺癌的預(yù)防知識,汗腺癌的癥狀圖片,汗腺癌吃什么藥,汗腺癌怎么治...
-
眶假瘤
628健康網(wǎng)為您分享有關(guān)眶假瘤的癥狀,眶假瘤的治療方法,眶假瘤的預(yù)防知識,眶假瘤的癥狀圖片,眶假瘤吃什么藥,眶假瘤怎么治...
-
闌尾類癌
628健康網(wǎng)為您分享有關(guān)闌尾類癌的癥狀,闌尾類癌的治療方法,闌尾類癌的預(yù)防知識,闌尾類癌的癥狀圖片,闌尾類癌吃什么藥,闌...
版權(quán)聲明:
1、本站內(nèi)容僅做參考,不能作為診斷及醫(yī)療的依據(jù)!
2、本文內(nèi)容來源于網(wǎng)絡(luò)或會員發(fā)布,版權(quán)歸原網(wǎng)站所有。
3、本站僅提供信息展示,不承擔(dān)相關(guān)法律責(zé)任。





